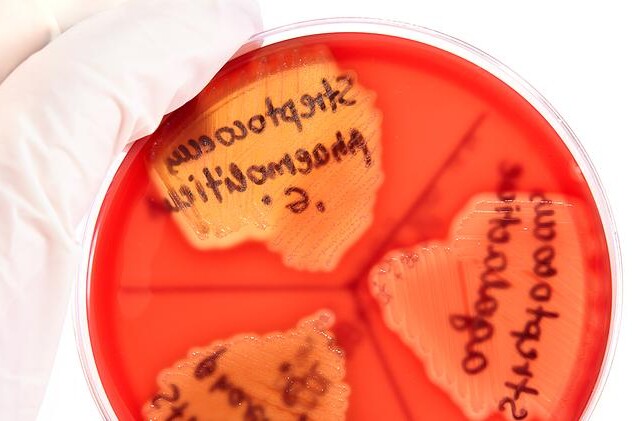
Erysipel neboli růže

Dehydratace je nedostatek tekutin v těle. Ohrožuje především děti a staré lidi.

Erysipel neboli růže je onemocnění kůže, které je nejčastěji způsobené bakterií zvanou streptokok. Projevy erysipelu jsou zprvu horečka, bolesti hlavy a nevolnost. Poté nastoupí samotné kožní projevy jako zarudnutí a bolestivost v místě poškozeném erysipelem. Komplikace může nastat v případě, kdy u těžkých puchýřovitých forem dojde k destrukci hlubších tkání, nebo když infekce pronikne až na svalovou vrstvu a vznikne rozsáhlý neohraničený zánět zvaný flegmóna.
Růže neboli erysipel je prudce probíhající onemocnění kůže, které kromě kůže postihuje i svrchní vrstvu podkoží. Ve většině případů je erysipel neboli růže způsoben streptokoky, přesněji beta hemolytickými streptokoky skupiny A. Jedná se o bakterie, které produkují toxické látky škodlivé pro náš organismus a mimo jiné způsobují i toto kožní onemocnění. Méně často je pak erysipel neboli růže způsoben jinými mikroorganismy. Na rozdíl od planých neštovic a některých dalších infekčních chorob, které zanechávají celoživotní imunitu, se může růže během života opakovat i několikrát. Nejvíce ohroženi jsou pak pacienti se sníženou imunitní odpovědí, jejichž tělo není schopno se bakteriální infekci dostatečně účinně bránit.
Erysipel neboli růže vzniká nejčastěji u pacientů se sníženou obranyschopností organismu, s bércovými vředy, po traumatech, nebo u pacientů trpících cukrovkou. Vstupní branou, tedy místem, kudy se streptokoky do kůže dostávají, jsou nejčastěji čerstvá nebo i starší poranění, např. rány po otevřených frakturách, trhliny v kůži, vředy, apod. Poranění však mohou být i mnohem menšího rozsahu, například pro průnik bakterií do organismu stačí i drobné prasklinky vznikající na kůži v okolí nosu při déletrvající rýmě. Bakterie proniknou do povrchových vrstev kůže, ale postupně se dostávají až do podkoží, přičemž k transportu využívají mízní cévy.
Erysipel neboli růže je akutně probíhající onemocnění, jehož projevy většinou nastupují náhle. U pacienta dochází k prudkému vzestupu teplot, což je reakce těla, které se usilovně snaží zastavit pronikající streptokokovou infekci. Horečka dosahuje obvykle kolem 40°C a je doprovázena zimnicí, celkovou únavou a schváceností, bolestmi hlavy a někdy také nevolností a zvracením. Do dvou dnů se pak objevují také kožní projevy, které jsou pro erysipel charakteristické. Jde o výrazné zarudnutí postiženého místa, které je navíc zvýšeně citlivé na dotek. Rudě zbarvené ložisko je obvykle doprovázeno otokem, bývá ostře ohraničené proti okolí a prstovitě se šíří na zdravou tkáň. Zpravidla také dochází ke zduření mízních uzlin v postižené oblasti. V obzvláště závažných případech se vytvářejí drobné nebo i veliké puchýře a dochází k rozsáhlejší destrukci kůže. V případě, že bakteriální infekce pronikne až na svalovou vrstvu, vzniká pak rozsáhlý neohraničený zánět, kterému se říká flegmóna.
Nejčastěji vzniká onemocnění zvané erysipel neboli růže na dolních nebo horních končetinách. Dále pak může vzniknout i na obličeji a méně často na pohlavních orgánech. Poměrně typickým rysem, a rovněž nejčastější komplikací, pro erysipel jsou tzv. recidivy, což znamená, že projevy onemocnění ustoupí, ale za nějaký čas se znovu navrátí a to často s ještě větší intenzitou. Toto znovunavrácení nemoci je způsobeno zvláštním obranným mechanismem bakterií, které jsou schopné přetrvávat v opouzdřené formě ve tkáni a jakmile dojde k oslabení organismu, znovu se aktivují a vyvolají tak další vlnu projevů erysipelu neboli růže. Rizikem recidivování erysipelu je poškození mízních cév, které vede k zadržování mízy, nejčastěji v končetinách, a tím ke vzniku viditelných mízních otoků, tzv. elefantiáza. Kvůli vzhledu ztluštělé kůže znamená pojem elefantiáza sloní nohu. S rizikem elefantiázy je třeba počítat a upozornit pacienta na možné důsledky poškození mízního systému. Další možnou komplikací je vznik kožního abscesu, tedy ohraničeného ložiska v kůži, které je vyplněno hnisem. Tento stav se obvykle řeší drobným chirurgickým zákrokem, kdy se absces vyřízne a rána se vyčistí. Potřeba je také úprava antibiotické léčby růže. Pozdější komplikací je vznik ledvinného onemocnění. K tomu dochází několik týdnů po erysipelu, zpravidla za jeden až čtyři týdny. Jedná se v podstatě o zánět ledvin, který ale musí být co nejdříve léčen. Ledviny mohou dosahovat značných rozměrů a výrazně tak omezovat pacientovu hybnost.
Diagnostika erysipelu neboli růže je založena na klinických projevech onemocnění, kdy se zaměřujeme na souvislost vysokých náhle vzniklých teplot se zarudnutím časti těla. Nejčastěji to bývají dolní končetiny. Je zapotřebí erysipel odlišit od tzv. celullitidy, která vypadá velice podobně, avšalk postihuje hlubší vrstvy kůže. K potvrzení erysipelu neboli kůže se provádí mikrobiologické vyšetření, při kterém se odebírá vzorek z oblasti vstupu infekce do těla a různými metodami se zjišťuje přítomnost streptokoka v organismu.
Při včas zahájené a pečlivě dodržované léčbě dochází obvykle k vyhojení kožních projevů i k ústupu horečky a dalších příznaků do dvou týdnů. Pokud se nejedná o komplikovanou formu erysipelu, podáváme antibiotika dle citlivosti přimo do žíly. Nejčastěji se podává penicillin po dobu 9 dnů. Pro potlačení bolesti a pálení v místě kožních projevů přikládáme chladivé obklady a nanášíme protizánětlivé masti.
Erysipel neboli růže je onemocnění, kterému je lepší předcházet. Dodržováním dostatečně vysoké hygieny jak v domácím prostředí, tak v nemocnicích lze zabránit vzniku erysipelu neboli růži. Právě proto je ve zdravotnických zařízeních kladen takový důraz na sterilní podmínky při ošetřování kožních poranění. Jen tak se totiž výrazně sníží pravděpodobnost zanesení infekce a vzniku dalších komplikací erysipelu.
Diskuze